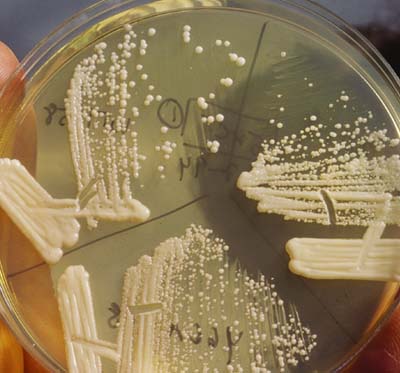
None

Entry
Reader's guide
Entries A-Z
Subject index
Antibiotics
Antibiotics are chemicals used to fight diseases caused by pathogens such as bacteria, fungi, or protozoa. Only a few antibiotics are effective against just a few viruses. Antibiotics can be used to fight infections because they are toxic to specific microbes. They may be prescribed to prevent infection when the immune system is impaired, or when there is a risk of endocarditis (inflammation of the lining of the heart). Before the advent of modern antibiotics, many patients experienced a uniform progression of the disease to the death. Antibiotics were originally produced from selected mold and fungi found in the earth, air, or water.
Since the 1930s, thousands of antibiotics have been found in nature; however, only a few (over 60) have been found to be safe for use as medicines. Most modern antibiotics are made synthetically by chemical means. Millions of tons of antibiotics are manufactured every year in a process that brews a culture of the microbe that produces the chemical that is the active agent in fighting a disease. After the antibiotic broth is filtered, the antibiotic molecules are combined with a resin that is washed to collect the pure antibiotic crystals.
In the late 1800s, a Danish bacteriologist, Hans Gram, classified bacterial infections as either gram positive (G+) or as gram negative (G-). Bacteria in these categories are sensitive to some drugs, and not to others. If an antibiotic fights only a few bacteria infections, it is called a limited-spectrum drug. If it fights a wide variety of bacteria that are both G+ and G-, it is called a broad-spectrum antibiotic. Bactericidal antibiotics are drugs that kill bacteria by causing a disruption in its cell walls, causing the bacterial cell wall to turn into water and allowing water to flood the cell. It then explodes, killing the bacteria. They do not have any affect upon human tissue. Other antibiotics are bacteriostatic drugs, which work by disrupting the growth of bacteria. This allows the immune system to have time for fighting successfully the infection. The most common forms of antibiotics include aminoglycosides, macrolides, penicillins, tetracyclines, and cephalosporins. Each works in a different way.
Antibiotics are manufactured by “brewing” a culture of the microbe that produces the active disease-fighting agent.
The aminoglycosides include drugs such as gentamicin, anikacin, and tobramycin, which prevent bacteria from producing protein; however, they can damage internal ear nerves and the kidneys. Macrolides also disrupt protein production by bacteria. Erythromycin, a macrolide, can cause bowel discomfort.
Sir Alexander Fleming discovered penicillin in 1928. Many kinds of bacteria are destroyed with penicillin drugs, which destroy bacteria cell walls. However, it can cause side effects ranging from a rash or fever, to life-threatening allergic reactions (anaphylaxis). Tetracyclines can destroy both bacteria and other organisms, and prevent the production of protein in many germs. However, side effects such as gastric discomfort, sensitivity of skin to sunlight, liver damage, or kidney damage may occur. The cephalosporins, which disrupt bacteria cell wall formation, are antibiotics that are effective against a wide range of bacteria. Cefaclor is a commonly prescribed cephalosporin. At times, physicians will prescribe a combination of antibiotics in order to ensure the destruction of the infectious bacteria and to reduce the risk of drug resistance. This can happens if a bacteria simply mutates, or if it is able to develop a growth mechanism that allows it to grow unaffected by the drug. Or, the bacteria may produce an enzyme that neutralizes the drug.
...
- Agriculture
- Agriculture
- Agroecosystems
- Agroforestry
- Agronomy
- Aquaculture
- Arbor Day
- Arid Lands
- Bananas
- Beneficial Use Doctrine
- Biotechnology
- Bureau of Land Management (U.S.)
- Cacao
- Cash Crop
- Cattle
- Coffee
- Collective Agriculture
- Community Gardens
- Composting
- Consumers, Ecological
- Crop Plants
- Crossbreeding
- Dandelions
- Department of Agriculture (U.S.)
- Domestication
- Farmers' Markets
- Farming Systems
- Farmland Conservation
- Fast Food
- Food
- Gardens
- Grazing
- Integrated Pest Management
- Irrigation
- Livestock
- Mad Cow Disease
- Meat
- No-Till Agriculture
- Organic Agriculture
- Parasites
- Pastoralism
- Pesticides
- Pests, Agricultural
- Plantation
- Plants
- Potatoes
- Precipitation
- Ranchers
- Rice
- Salmon
- Seasons
- Seed Bank
- Seeds, Agrodiversity and
- Sheep
- Smallholders
- Soil Science
- Soils
- Soybeans
- Sugar
- Terraces and Raised Fields
- Tobacco
- Tomato
- United Farm Workers
- Urban Gardening and Agriculture
- Weather
- Wheat
- Animals
- Amphibians
- Animal Rights
- Animals
- Animism
- Aquaculture
- Aquariums
- Arctic National Wildlife Refuge
- Balance-of-Nature Paradigm
- Bison
- Black Death
- Boll Weevil
- Bovine Growth Hormone
- Bovine Spongiform Encephalopathy
- Cane Toad
- Cattle
- Chimpanzees
- Circuses
- Cloning
- Communication, Interspecies
- Crossbreeding
- Deer
- Dodo Bird
- Dogs
- Dolphins
- Domestication
- Elephants
- Endangered Species
- Endangered Species Act (1973)
- Evolution
- Extinction of Species
- Fire Ant
- Fish and Wildlife Service (U.S.)
- Fish Ladders
- Fisheries
- Food Webs (or Food Chains)
- Fossey, Dian
- Genetics and Genetic Engineering
- Goodall, Jane
- Grazing
- Habitat Protection
- Herders
- Hunting
- Insects
- Integrated Pest Management
- Invasive Species
- Keystone Species
- Lab Animals
- Livestock
- Mad Cow Disease
- Meat
- Migration
- Mosquitoes
- National Marine Fisheries Service
- Native Species
- Northern Spotted Owl
- Overfishing
- Overgrazing
- Overkill Hypothesis
- Overpopulation
- Parasites
- Passenger Pigeon
- Pesticides
- Pests, Agricultural
- Pets
- Poaching
- Predator/Prey Relations
- Primates
- Safaris
- Salmon
- Save the Whales Movement
- Sea Turtles
- Sheep
- Shrimp
- Species
- Tigers
- Tobacco
- Tuna Fishing
- Vegetarianism
- Whales and Whaling
- Wild Horses
- Wild versus Tame
- Wildlife
- Wolves
- Zoos
- Biology and Chemistry
- Acquired Immune Deficiency Syndrome (AIDS)
- Allergen
- Analytical Chemistry
- Antibiotics
- Arsenic
- Asbestos
- Atrazine
- Biocentrism
- Biodiversity
- Bioenergy
- Biogeochemical Cycle
- Biological Oxygen Demand
- Biomagnification
- Biomes
- Biophilia
- Biopiracy
- Bioprospecting
- Bioregionalism
- Biosphere
- Biosphere Reserves
- Biotechnology
- Botany
- Brucellosis
- Bt (Bacillus Thuringiensis)
- BT Toxoid
- Chromosomes
- Conservation Biology
- Convention on Biodiversity
- Cryptosporidium
- DDT
- Deoxyribonucleic Acid
- Disease
- Drugs
- Fecal Coliform Bacteria
- Gene Therapy
- Genetic Diversity
- Genetic Patents
- Genetically Modified Organisms
- Genetics and Genetic Engineering
- Green Chemistry
- Health
- Human Genome Project
- Mad Cow Disease
- Malaria
- Malnutrition
- Mercury
- Methane
- Methyl Tertiary-Butyl Ether
- Microbes
- Mold
- Mutation
- Opium (and Heroin)
- Organophosphates
- Oxygen
- Polychlorinated Biphenals
- Radioactivity
- Sex
- Sexually Transmitted Diseases
- Silicosis
- Smoking
- Sterilization
- Syphilis
- Toxaphene
- Toxic Releases Inventory
- Transmissible Spongiform Encephalopathies
- Trichloroethylene
- Vaccination
- Volatile Organic Compounds
- Climate
- Air Conditioning
- Arid Lands
- Blizzards
- Butterfly Effect
- Climate
- Climate Modeling
- Climate, Arctic and Subarctic
- Climate, Arid and Semi-Arid
- Climate, Continental
- Climate, Humid Subtropical
- Climate, Marine West Coast
- Climate, Mediterranean
- Climate, Tropical
- Climatology
- Currents, Ocean
- Desertification
- Drought
- Dryland Farming
- Earthquake
- Everglades
- Floods and Flood Control
- Framework Convention on Climate Change
- Glaciers
- Global Environmental Change
- Global Warming
- Hadley Cell
- Heat
- Heat Island Effect
- Heat Wave
- Humidity
- Hurricanes
- Ice Ages
- Intergovernmental Panel on Climate Change
- Microclimates
- Seasons
- Solar Energy
- Thunderstorms
- Tides
- Tornadoes
- Trade Winds
- Tropics
- Tsunamis
- Tundra
- Union of Concerned Scientists
- United Nations Framework Convention on Climate Change
- Variability
- Weather
- Weather Modification
- Conservation and Ecology
- Adaptation
- Adaptive Management
- Agroecosystems
- Agronomy
- Alternative Energy
- Arbor Day
- Arctic National Wildlife Refuge
- Atmosphere
- Atmospheric Science
- Balance-of-Nature Paradigm
- Boreal Forest
- Butterfly Effect
- Central Park (NY)
- Clear-Cutting
- Community Forestry
- Community Gardens
- Community-Based Conservation
- Conservation
- Conservation Biology
- Conservation Easements
- Conservation Reserve Program
- Coral Reefs
- Cultural Ecology
- Dams
- Deep Ecology
- Deforestation
- Dendrochronology
- Deposit-Return Charges
- Disequilibrium
- Drilling
- Earth Day
- Earth First!
- Eastern Wilderness Act
- Ecological Footprint
- Ecological Imperialism
- Ecological Modernization
- Ecology
- Ecosystem
- Ecotone
- Eden, Garden of
- Edge Effect
- Environmental Protection Agency
- Everglades
- Farmland Conservation
- Forest Service
- Garden Cities
- Glacier National Park
- Habitat Protection
- Human Ecology
- Industrial Ecology
- Joint Forest Management
- Land and Water Conservation Fund Act
- Landscape Ecology
- League of Conservation Voters
- Long Term Ecological Research Network
- Marine Science
- Migration
- National Geographic Society
- National Parks
- Nature Conservancy
- Nixon, Richard Administration
- Olmstead, Frederick Law
- Overpopulation
- Pests, Agricultural
- Political Ecology
- Predator/Prey Relations
- Preservation
- Protected Areas
- Reclamation Act
- Recycling
- Redundancy, Ecological
- Resilience, Ecological
- Resource Conservation and Recovery Act
- Restoration Ecology
- Salmon
- Save the Whales Movement
- Sierra Club
- Social Ecology
- Solar Energy
- United Nations Environment Programme
- Urban Ecology
- Urban Parks Movement
- Vertical Ecology
- Water Conservation
- Wind Energy
- World Conservation Union
- Xeriscape
- Yellowstone National Park
- Yosemite National Park
- Countries
- Afghanistan
- Albania
- Algeria
- Angola
- Argentina
- Armenia
- Australia
- Austria
- Azerbaijan
- Bahrain
- Bangladesh
- Belarus
- Belgium
- Belize
- Benin
- Bhutan
- Bolivia
- Bosnia and Herzegovina
- Botswana
- Brazil
- Bulgaria
- Burkina Faso
- Burundi
- Cambodia
- Cameroon
- Canada
- Cape Verde
- Central African Republic
- Chad
- Chile
- China
- Colombia
- Congo
- Congo, Democratic Republic
- Costa Rica
- Croatia
- Cuba
- Cyprus
- Czech Republic
- East Timor
- Ecuador
- Egypt
- El Salvador
- Equatorial Guinea
- Eritrea
- Estonia
- Ethiopia
- European Union
- Finland
- France
- Gabon
- Gambia
- Georgia (Nation)
- Germany
- Ghana
- Greece
- Guam
- Guatemala
- Guinea
- Guinea-Bissau
- Guyana
- Haiti
- Honduras
- Hungary
- Iceland
- India
- Indonesia
- Iran
- Iraq
- Ireland
- Israel
- Italy
- Ivory Coast
- Jamaica
- Japan
- Jordan
- Kazakhstan
- Kenya
- Korea, North
- Korea, South
- Kudzu
- Kuwait
- Kyrgyzstan
- Laos
- Latvia
- Lebanon
- Lesotho
- Liberia
- Libya
- Lithuania
- Macedonia
- Madagascar
- Malawi
- Malaysia
- Maldives
- Mali
- Mauritania
- Mauritius
- Mexico
- Micronesia
- Moldova
- Mongolia
- Morocco
- Mozambique
- Myanmar
- Namibia
- Nauru
- Nepal
- Netherlands
- New Caledonia
- New Zealand
- Nicaragua
- Niger
- Nigeria
- Norway
- Oman
- Pakistan
- Panama
- Papua New Guinea
- Paraguay
- Peru
- Philippines
- Poland
- Portugal
- Puerto Rico
- Qatar
- Romania
- Russia (and Soviet Union)
- Rwanda
- Samoa
- Saudi Arabia
- Senegal
- Serbia and Montenegro
- Sierra Leone
- Singapore
- Slovakia
- Slovenia
- Somalia
- South Africa
- Spain
- Sri Lanka
- Sudan
- Suriname
- Swaziland
- Sweden
- Switzerland
- Syria
- Taiwan
- Tajikistan
- Tanzania
- Thailand
- Togo
- Tunisia
- Turkey
- Turkmenistan
- Uganda
- Ukraine
- United Kingdom
- United States, Alaska
- United States, California
- United States, Central South
- United States, Great Plains
- United States, Gulf Coast South
- United States, Hawaii
- United States, Middle Atlantic
- United States, Midwest
- United States, Mountain West
- United States, Northeast
- United States, Pacific Northwest
- United States, Southeast
- United States, Southwest
- United States, Texas
- Uruguay
- Uzbekistan
- Venezuela
- Vietnam
- Yemen
- Zambia
- Zimbabwe
- Geography
- Amazon River Basin
- Andes Mountains
- Antarctica
- Appalachian Mountains
- Arctic
- Arid Lands
- Atlantic Ocean
- Baikal, Lake
- Basin
- Beaches
- Black Sea
- Boreal Forest
- Cape Verde
- Caribbean Sea
- Caspian Sea
- Chang Jiang (Yangtze) River
- Cities
- Cloud Forests
- Coastal Zone
- Colorado River
- Congo River and Basin
- Coniferous Forest
- Continental Shelf
- Continents
- Coral Reefs
- Croton River Aqueduct
- Danube River
- Deciduous Forest
- Desert
- Dunes
- Erie, Lake
- Everest, Mount
- Floodplains
- Fuji, Mount
- Geography
- Glaciers
- Gobi Desert
- Grand Canyon
- Grasslands
- Hoover Dam
- Huang (Yellow) River
- Indian Ocean
- Kalahari Desert
- Kilimanjaro, Mount
- Klamath Basin
- Lakes
- Latitude
- Locks and Dams
- Longitude
- Los Angeles River
- Mediterranean Sea
- Mekong River
- Mississippi River
- Mountains
- Nile River (and White Nile)
- Oasis
- Ob-Irtysh River
- Oceans
- Owens Valley
- Pacific Ocean
- Persian Gulf
- Prairie
- Rain Forests
- Rhine River and Valley
- Rio Grande
- Rivers
- Rocky Mountains
- Sahara Desert
- Savanna (or Tropical Grassland)
- Steppe
- Tanganyika, Lake
- Thar Desert
- Three Gorges Dam
- Tigris and Euphrates Rivers
- Titicaca, Lake
- Topographic Maps
- Tropical Forests
- Tundra
- Ural Mountains
- Victoria, Lake
- Volga River
- Yucca Mountain
- History
- Exxon Valdez
- Geer vs. Connecticut
- Gibbons vs. Ogden
- Martin vs. Waddell
- Tyler vs. Wilkinson
- Addams, Jane
- Antiquities Act
- Aristotle
- Bhopal Gas Tragedy
- Black Death
- Bookchin, Murray
- Bosnia and Herzegovina
- Bush, George H.W. Administration
- Bush, George W. Administration
- Carter, Jimmy Administration
- Chernobyl Accident
- Clinton, William Administration
- Colonialism
- Communism
- Darwin, Charles
- Dust Bowl, U.S.
- Energy Crisis (1973)
- Enron
- Gore, Al
- Humboldt, Alexander von
- Ice Ages
- Industrial Revolution
- Kennedy, John F. Administration
- Lewis and Clark Expedition
- Locke, John
- Marx, Karl
- Nader, Ralph
- Nixon, Richard Administration
- Postcolonialism
- Progressive Party
- Reagan, Ronald Administration
- Reclamation Act
- Roosevelt, Theodore Administration
- Rousseau, Jean Jacques
- Sinclair, Upton
- Social Darwinism
- Socialism
- Supreme Court Decisions
- Tennessee Valley Authority
- Thatcher, Margaret
- Three Mile Island Accident
- Totalitarianism
- United Nations
- Wars
- Movements and Regulations
- Agenda 21
- Alliance of Small Island States
- Alternative Energy
- Animal Rights
- Antiquities Act
- Basel Convention
- Buffalo Commons
- Cairo Guidelines on Waste Trading (UN)
- Car Corporate Average Fuel Economy Standards
- Carpooling
- Chipko Andolan Movement
- Clean Air Act
- Clean Water Act
- Cloning
- Collective Agriculture
- Command and Control Regulation
- Commerce Clause
- Communism
- Community-Based Conservation
- Comprehensive Environmental Response Compensation and Liability Act
- Conservation
- Convention on Biological Diversity
- Convention on International Trade in Species of Wild Fauna and Flora
- Cradle-to-Grave Regulation of Hazardous Waste
- Cultural Ecology
- Delaney Amendment
- Deregulation
- Dryland Farming
- Earth Day
- Earth First!
- Eastern Wilderness Act
- Ecofeminism
- Ecological Modernization
- Endangered Species Act
- Environmentalism
- Eugenics
- Farmland Conservation
- Federal Insecticide, Fungicide, and Rodenticide Act
- Federal Land Policy and Management Act
- Feng Shui
- Forest Organic Act
- Framework Convention on Climate Change
- General Agreement on Tariffs and Trade
- General Mining Law
- Globalization
- Green Movement
- Green Revolution
- Historical Materialism
- Human Genome Project
- Hybrid Vehicle
- Industrial Revolution
- Intergovernmental Panel on Climate Change
- International Tropical Timber Agreement
- Kyoto Protocol
- Land and Water Conservation Fund Act
- Litigation, Environmental
- Lobbyists
- Modernity
- Montreal Protocol
- Movements, Environmental
- National Forest Management Act
- National Wild and Scenic Rivers Act
- Nature Conservancy
- North American Free Trade Agreement
- Nuisance Law
- One Child Policy, China
- Pastoralism
- Policy, Environmental
- Political Ecology
- Prescribed Burning
- Preservation
- Protected Areas
- Public Land Management
- Reclamation Act
- Recycling
- Reforestation
- Renewable Energy
- Resource Conservation and Recovery Act
- Rural Gentrification
- Safe Drinking Water Act
- Salinization
- Save the Whales
- Sewer Socialism
- Slow Food Movement
- Social Darwinism
- Social Ecology
- Socialism
- Sociobiology
- Sociology
- Space Program
- Sterilization
- Supreme Court Decisions
- Swamp Lands Acts
- Taylor Grazing Act
- Totalitarianism
- Trade, Fair
- Trade, Free
- Transcendentalism
- United Nations Framework Convention on Climate Change
- Urban Ecology
- Urban Parks Movement
- Vegetarianism
- Water Conservation
- Water Law
- Weather Modification
- Wilderness Act of 1964
- Organizations
- Army Corps of Engineers
- Audubon Society
- Bureau of Land Management
- Bureau of Reclamation (U.S.)
- Center for Disease Control
- Club of Rome
- Conservation Reserve Program
- Consultive Group for International Agricultural Research
- Department of Agriculture (U.S.)
- Department of Energy (U.S.)
- Department of the Interior (U.S.)
- Environmental Protection Agency
- Federal Emergency Management Agency
- Fish and Wildlife Service (U.S.)
- Food and Drug Administration
- Forest Service
- General Agreement on Tariffs and Trade
- German Royal Forest Academy
- Greenpeace
- Institutions
- Integrated Pest Management
- Intergovernmental Panel on Climate Change
- International Monetary Fund
- Joint Forest Management
- League of Conservation Voters
- Long Term Ecological Research Network
- Man and the Biosphere Program
- National Geographic Society
- National Marine Fisheries Service
- National Oceanic and Atmospheric Administration
- National Parks Service
- Natural Resource Conservation Service
- Natural Resources Defense Council
- Non-Governmental Organizations
- Nuclear Regulatory Commission
- Organization of Petroleum Exporting Countries
- Progressive Party
- Public-Private Partnerships
- Risk Society
- Save the Whales Campaign
- Sierra Club
- Tennessee Valley Authority
- Think Tanks
- UNESCO
- Union of Concerned Scientists
- United Farm Workers
- United Nations
- United Nations Environment Programme
- United States Geological Survey
- Wilderness Society
- Women's Environment and Development Organization
- World Bank
- World Conservation Union
- World Health Organization
- World Trade Court
- World Trade Organization
- World Wildlife Fund
- Worldwatch Institute
- People
- Abbey, Edward
- Addams, Jane
- Aristotle
- Berry, Wendell
- Blaut, James
- Bookchin, Murray
- Boserup, Ester
- Botkin, Daniel
- Braudel, Fernand
- Brockovich, Erin
- Brower, David
- Bullard, Robert
- Carson, Rachel
- Chavez, Cesar
- Clemens, Frederic
- Commoner, Barry
- Cronon, William
- Darwin, Charles
- Diamond, Jared
- Downing, Andrew Jackson
- Ehrlich, Paul
- Fossey, Dian
- Gibbs, Lois
- Glacken, Clarence
- Goodall, Jane
- Gore, Al
- Guha, Ramachandra
- Hamilton, Alice
- Haraway, Donna
- Hardin, Garrett
- Humboldt, Alexander von
- Huntington, Ellsworth
- Kropotkin, Peter
- Leaky, Louis and Mary
- Leaky, Richard
- Leopold, Aldo
- Linnaeus, Carl
- Locke, John
- Lorenz, Konrad
- Maathai, Wangari
- Malthus, Thomas
- Marsh, George Perkins
- Marx, Karl
- Mendes, Chico
- Merchant, Carolyn
- Muir, John
- Mumford, Lewis
- Nader, Ralph
- Naess, Arne
- Nietschmann, Bernard
- Odum, Eugene
- Olmstead, Frederick Law
- Pasteur, Louis
- Patkar, Medha
- Pinchot, Gifford
- Powell, John Wesley
- Rappaport, Roy
- Reclus, Elisee
- Rousseau, Jean Jacques
- Sachs, Wolfgang
- Sauer, Carl
- Schumacher, E.F.
- Scott, James C.
- Semple, Ellen Churchill
- Sen, Amartya
- Shiva, Vandana
- Simon, Julian
- Sinclair, Upton
- Somerville, Mary
- Thatcher, Margaret
- Thoreau, Henry David
- Udall, Morris
- Watt, James G.
- White, Gilbert
- White, Gilbert (20th century)
- Wittfogel, Karl A.
- Worster, Donald
- Wright, Frank Lloyd
- Politics
- Addams, Jane
- Alliance of Small Island States
- Animal Rights
- Capitalism
- Carter, Jimmy Administration
- Clinton, William Administration
- Cloning
- Colonialism
- Communism
- Consumers, Economic
- Culture
- Decision Science
- Democracy
- Department of Agriculture (U.S.)
- Department of Energy (U.S.)
- Department of the Interior (U.S.)
- Developed (First) World
- Ecofeminism
- Economics
- Ethics
- Evolution
- Feminist Political Ecology
- Framework Convention on Climate Change
- Global Warming
- Globalization
- Gore, Al
- Gross National Product (and GDP)
- Ideology
- Industrialization
- Intergovernmental Panel on Climate Change
- International Monetary Fund
- Kennedy, John F. Administration
- Kyoto Protocol
- League of Conservation Voters
- Litigation, Environmental
- Lobbyists
- Locke, John
- Marsh, George Perkins
- Marx, Karl
- Mass Media
- Montreal Protocol
- Nader, Ralph
- Nixon, Richard Administration
- North American Free Trade Agreement
- Nuclear Weapons
- Organization of Petroleum Exporting Countries
- Palestine
- Postcolonialism
- Pragmatism
- Progressive Party
- Race
- Race-to-the-Bottom Hypothesis
- Reagan, Ronald Administration
- Religion
- Roosevelt, Theodore Administration
- Scarcity
- Second Contradiction of Capitalism
- Sinclair, Upton
- Social Darwinism
- Socialism
- Supreme Court Decisions
- Tennessee Valley Authority
- Thatcher, Margaret
- Think Tanks
- Totalitarianism
- Underdeveloped (“Third”) World
- UNESCO
- United Nations
- United Nations Framework Convention on Climate Change
- War on Drugs
- Watt, James G.
- Weapons of Mass Destruction
- World Trade Organization
- Pollution
- Acid Rain
- Agent Orange
- Alaska Pipeline
- Alternative Energy
- Appropriate Technology
- Arsenic
- Asbestos
- Automobiles
- Basel Convention
- Best Available Technology
- Bhopal Gas Tragedy
- Bikini Atoll
- Brockovich, Erin
- Cairo Guidelines on Waste Trading
- Cancer Alley
- Car Corporate Average Fuel Economy Standards
- Carbon Dioxide
- Carbon Tax
- Carcinogens
- Catalytic Converters
- Chlorinated Hydrocarbons
- Chlorofluorocarbons
- Circle of Poison
- Clean Air Act
- Clean Water Act
- Coal
- Cradle-to-Grave Regulation of Hazardous Waste
- DDT
- Department of Energy
- Deregulation
- Dioxins
- Earth Day
- Economics
- Environmental Protection Agency
- Extinction of Species
- Federal Insecticide, Fungicide, and Rodenticide Act
- Food Irraditation
- Fossil Fuels
- Framework Convention on Climate Change
- Garbage
- Gasoline
- Global Environmental Change
- Global Warming
- Green Chemistry
- Green Consumerism
- Green Movement
- Green Production and Industry
- Green Revolution
- Greenhouse Effect
- Greenhouse Gases
- Groundwater
- Hybrid Vehicle
- Hydrogen Fuel
- Hydropower
- Industrialization
- Inversion, Temperature
- Kyoto Protocol
- Montreal Protocol
- Mutation
- Natural Gas
- Nitrogen Oxides
- Nixon, Richard Administration
- Nonpoint Source Pollution
- Oil Spills
- Ozone and Ozone Depletion
- Paleoclimatology
- Petroleum
- Point Source Pollution
- Pollution, Air
- Pollution, Water
- Polychlorinated Biphenals
- Renewable Energy
- Safe Drinking Water Act
- Salinization
- Uranium
- Urban Parks Movement
- Urbanization
- Wastewater
- Society
- Acquired Immune Deficiency Syndrome
- Agent Orange
- Animal Rights
- Anthropocentrism
- Anthropology
- Audubon Society
- Automobiles
- Bhopal Gas Tragedy
- Bicycle
- Birth Control
- Birth Rate
- Black Death
- Body, Human
- Capitalism
- Carcinogens
- Carpooling
- Central Planning
- Chaos Theory
- Chernobyl Accident
- Cities
- Cloning
- Cocaine
- Coffee
- Common Law
- Common Property Theory
- Communism
- Commuting
- Culture
- Death of Nature
- Death Rate
- Debt
- Democracy
- Democratic Collapse
- Design and Ecodesign
- Developed (First) World
- Diffusionism
- Disasters
- Disease
- Domination of Nature
- Drinking Water
- Drugs
- Economics
- Education
- Efficiency
- Energy
- Environmental Racism
- Epidemic
- Ethics
- Evolution
- Fast Food
- Fire
- Flight
- Food
- Globalization
- Health
- Highways
- Infant Mortality Rate
- Justice
- Landfills
- Lawns
- Life Expectancy
- Malnutrition
- Markets
- Mass Media
- Megalopolis
- Monoculture
- Needs and Wants
- NIMBY
- Obesity
- Peasants
- Pets
- Population
- Poverty
- Quality of Life
- Race
- Recycling
- Religion
- Sewage and Sewer Systems
- Sex
- Sexually Transmitted Diseases
- Smoking
- Social Darwinism
- Social Ecology
- Sociology
- Sport Utility Vehicles
- Suburbs
- Syphilis
- Technology
- Totalitarianism
- Tourism
- Underdeveloped (Third) World
- Urban Growth Control
- Urban Planning
- Urban Sprawl
- Urbanization
- Vaccination
- Vegetarianism
- Viruses
- War on Drugs
- Wars
- Waste Incineration
- Waste, Human
- Waste, Solid
- Water Quality
- Wilderness Society
- Wind Energy
- Wine
- Wise Use Movement
- Workplace Hazards
- World Wildlife Fund
- Zero Population Growth
- Loading...
Get a 30 day FREE TRIAL
-
Watch videos from a variety of sources bringing classroom topics to life
-
Read modern, diverse business cases
-
Explore hundreds of books and reference titles
Sage Recommends
We found other relevant content for you on other Sage platforms.
Have you created a personal profile? Login or create a profile so that you can save clips, playlists and searches